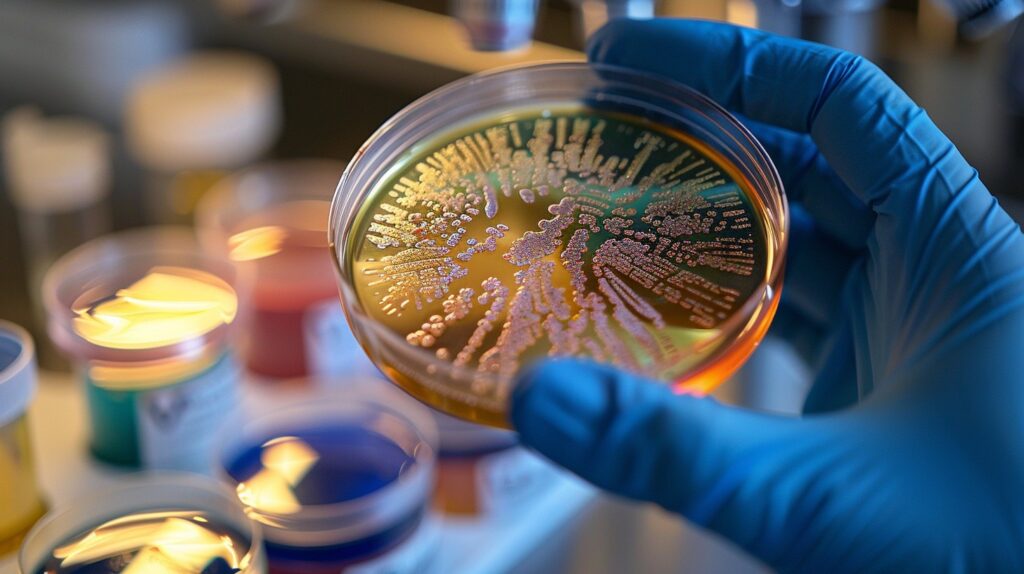
antibiotic resistance antibiotic resistance

Antibiotics once seemed like humanity’s ultimate victory over infectious disease. A simple pill could cure pneumonia, stop sepsis, and save millions of lives. For decades, these miracle drugs transformed medicine, making surgery safer, childbirth less dangerous, and once-deadly infections easily treatable. But antibiotic resistance is ending that era — and fast. Antibiotic resistance occurs when bacteria evolve to survive the drugs designed to kill them, turning treatable infections into deadly threats. Today, antibiotic resistance spreads silently across every country, creating superbugs that no medicine can stop and threatening to undo a century of medical progress.
But that era is ending.
Antibiotic resistance is silently spreading across the globe, turning common bacteria into untreatable superbugs. Infections that doctors could easily cure just years ago now kill patients in modern hospitals. The World Health Organization calls antibiotic resistance one of the biggest threats to global health, food security, and development. Yet most people remain unaware of this looming crisis.
This is not a distant future problem. Antibiotic resistance is happening right now, in every country, affecting people of all ages. If current trends continue, routine surgeries could become life-threatening, minor cuts could turn fatal, and we may return to a pre-antibiotic era where simple infections kill millions.
Antibiotic Resistance Explained: Understanding the Silent Threat
Antibiotic resistance occurs when bacteria evolve and develop the ability to defeat the drugs designed to kill them. When bacteria become resistant, antibiotics that once worked effectively no longer cure infections. The bacteria survive, continue to multiply, and can spread to other people.
This is not about your body becoming resistant to antibiotics — it is the bacteria themselves that become resistant. Each time bacteria survive an antibiotic treatment, they pass resistance genes to their offspring. Over time, entire populations of bacteria become immune to multiple antibiotics, creating what scientists call “superbugs.”
How antibiotic resistance develops:
- Bacteria naturally mutate: Some bacteria randomly develop genetic changes that help them survive antibiotics
- Antibiotics create selection pressure: When people take antibiotics, susceptible bacteria die, but resistant bacteria survive
- Resistant bacteria multiply: The surviving bacteria reproduce rapidly, creating millions of resistant copies
- Resistance genes spread: Bacteria share resistance genes with other bacteria, even across different species
- Superbugs emerge: Eventually, bacteria develop resistance to multiple antibiotics, becoming nearly impossible to treat
The more people use antibiotics — and especially when they misuse them — the faster bacteria develop resistance. This process is accelerating globally, and humanity is losing effective antibiotics faster than scientists can develop new ones.
History of Antibiotic Resistance: From Miracle Cure to Failing Weapon
The Golden Age of Antibiotics: Before Antibiotic Resistance
The story of antibiotics began in 1928 when Alexander Fleming accidentally discovered penicillin. He noticed that a mold growing on a bacterial culture killed the surrounding bacteria. This chance observation revolutionized medicine.
By the 1940s, penicillin was mass-produced and saved countless soldiers’ lives during World War II. For the first time in human history, doctors could cure bacterial pneumonia, strep throat, syphilis, and infected wounds with a simple injection.
The decades that followed became the golden age of antibiotics. Scientists discovered dozens of new antibiotic classes — streptomycin, tetracycline, erythromycin, vancomycin, and many others. Each new drug seemed like another victory against infectious disease. Child mortality plummeted. Life expectancy soared. Surgery became routine. Medicine entered a new era of confidence.
The Warning Signs of Antibiotic Resistance Emerge
But Fleming himself warned about resistance in his 1945 Nobel Prize speech. He observed that when bacteria faced non-lethal doses of penicillin, some survived and became resistant. His warning went largely unheeded.
By the 1950s and 1960s, resistance to penicillin and other early antibiotics was already appearing in hospitals. Staphylococcus aureus — a common bacteria that causes skin infections — quickly developed penicillin resistance. Scientists created methicillin to combat these resistant strains, but within a year, methicillin-resistant Staphylococcus aureus (MRSA) emerged.
This pattern has repeated with every new antibiotic class. Scientists create a new drug, bacteria develop resistance within months or years, and the cycle continues. Each generation of antibiotics works for a shorter period before resistance emerges.
The Antibiotic Discovery Pipeline Dries Up
The most alarming trend is that pharmaceutical companies have largely abandoned antibiotic research. The last major class of antibiotics was discovered in the 1980s. Since then, very few truly novel antibiotics have reached the market.
Why? Economics. Antibiotics are not profitable compared to drugs that treat chronic conditions. Patients take antibiotics for days or weeks, not years. Doctors reserve new antibiotics as “last resort” treatments, limiting their use. Developing a new antibiotic costs hundreds of millions of dollars, but resistance often appears within years of approval.
Major pharmaceutical companies have closed their antibiotic research divisions. The pipeline of new drugs is nearly empty precisely when humanity needs them most.
Major Causes of Antibiotic Resistance: How We Created This Crisis
Overuse and Misuse: Major Drivers of Antibiotic Resistance in Medicine
One of the primary drivers of antibiotic resistance is inappropriate antibiotic use in human healthcare. Doctors prescribe antibiotics far too often, and patients frequently misuse them.
Common misuse patterns:
- Prescribing for viral infections: Antibiotics kill bacteria, not viruses. Yet doctors routinely prescribe them for colds, flu, and viral bronchitis where they provide zero benefit
- Incomplete treatment courses: Patients stop taking antibiotics once they feel better, leaving surviving bacteria to multiply and develop resistance
- Wrong antibiotic choice: Using broad-spectrum antibiotics when narrow-spectrum drugs would work creates unnecessary selection pressure
- Patient pressure: Doctors sometimes prescribe antibiotics because patients demand them, even when medically unnecessary
- Over-the-counter availability: In many countries, people buy antibiotics without prescriptions and self-medicate incorrectly
Studies estimate that 30-50% of antibiotic prescriptions in human medicine are unnecessary or inappropriate. Every unnecessary prescription accelerates resistance.
Antibiotic Overuse in Agriculture: Accelerating Drug Resistance
The majority of antibiotics globally are not used in humans — they are used in food-producing animals. Farmers routinely give antibiotics to livestock not to treat sick animals, but to promote faster growth and prevent disease in crowded conditions.
This practice creates perfect conditions for resistance to develop:
- Animals receive low doses of antibiotics continuously through feed or water
- Bacteria in animal intestines face constant antibiotic exposure
- Resistant bacteria develop and spread through feces into soil, water, and food
- Humans consume resistant bacteria through undercooked meat or contaminated produce
- Farm workers carry resistant bacteria back to communities
Some estimates suggest that over 70% of medically important antibiotics sold globally are used in food animals, not humans. Many of these are the same antibiotics doctors rely on to treat serious human infections.
Countries with strict regulations on agricultural antibiotic use show lower resistance rates, proving this practice directly drives the resistance crisis.
Poor Infection Control: How Hospitals Spread Antibiotic Resistance
Hospitals and healthcare facilities ironically accelerate antibiotic resistance. Sick patients with weakened immune systems, invasive medical procedures, and concentrated antibiotic use create ideal breeding grounds for resistant bacteria.
How hospitals spread resistance:
- Patient-to-patient transmission: Resistant bacteria spread through healthcare worker hands, contaminated equipment, and surfaces
- Inadequate sanitation: Poor hand hygiene and cleaning practices allow resistant bacteria to persist
- Overuse of antibiotics: Hospitals prescribe more antibiotics than any other setting, creating intense selection pressure
- International medical tourism: Patients travel between countries, spreading resistant strains globally
Healthcare-associated infections now commonly involve multidrug-resistant organisms. Patients enter hospitals for routine procedures and leave with untreatable infections.
Lack of New Antibiotics: The Drug-Resistant Bacteria Gap
While bacteria evolve new resistance mechanisms constantly, humans develop new antibiotics rarely. The antibiotic discovery pipeline has virtually dried up.
Since the 1980s, pharmaceutical investment in antibiotic research has collapsed. The business model does not work — antibiotics cure patients quickly, limiting profit potential compared to drugs treating chronic diseases that patients take for decades.
Regulatory hurdles for new antibiotics are high, development costs enormous, and patent protection limited. By the time a new antibiotic reaches market, resistance may already be developing.
This imbalance — rapid bacterial evolution versus slow human innovation — defines the antibiotic resistance crisis.
Environmental Spread of Antibiotic Resistance
Antibiotics enter the environment through multiple pathways:
- Hospital and pharmaceutical waste: Antibiotic residues discharge into sewage systems
- Agricultural runoff: Animal waste containing antibiotics contaminates waterways
- Human excretion: People and animals excrete antibiotics into sewage
- Pharmaceutical manufacturing: Some countries have factories that discharge antibiotic waste directly into rivers
Environmental bacteria exposed to these residues develop resistance. Rivers, soil, and water supplies become reservoirs of resistance genes that can transfer back to human pathogens.
Dangerous Superbugs: Drug-Resistant Bacteria We Can No Longer Stop
MRSA: Methicillin-Resistant Staphylococcus Aureus
MRSA was one of the first widely recognized superbugs and remains a major global threat. This bacteria causes skin infections, pneumonia, bloodstream infections, and surgical site infections.
MRSA infections that once occurred only in hospitals now spread in communities — gyms, schools, prisons, and sports facilities. Once easily treatable with common antibiotics, MRSA now requires powerful intravenous drugs. Some MRSA strains resist nearly all available antibiotics.
MRSA kills tens of thousands of people annually in developed countries alone. In many regions, more than half of staph infections are now methicillin-resistant.
CRE: Carbapenem-Resistant Enterobacteriaceae
CRE bacteria resist carbapenems — antibiotics that doctors consider “last resort” treatments. When carbapenems fail, doctors often have no effective alternatives left.
CRE infections primarily affect hospitalized patients, especially those in intensive care units. These bacteria cause urinary tract infections, pneumonia, and bloodstream infections with mortality rates approaching 50% despite aggressive treatment.
The U.S. Centers for Disease Control calls CRE “nightmare bacteria” because they resist nearly all antibiotics and spread resistance genes to other bacteria rapidly. Once CRE enters a healthcare facility, eliminating it is extremely difficult.
XDR-TB: Extensively Drug-Resistant Tuberculosis
Tuberculosis has plagued humanity for millennia. Modern antibiotics finally made TB curable with a six-month treatment regimen. But drug-resistant TB now threatens to make this ancient killer untreatable again.
Multidrug-resistant TB (MDR-TB) resists the two most powerful first-line antibiotics. Treatment requires more toxic drugs for 18-24 months with lower cure rates.
Extensively drug-resistant TB (XDR-TB) resists most second-line drugs as well. Treatment options are limited, expensive, toxic, and often fail. Some XDR-TB strains are virtually untreatable.
Drug-resistant TB spreads in communities through the air. When patients with resistant TB cough, they spread resistant bacteria to others. This creates an expanding pool of people with difficult-to-treat or untreatable TB.
NDM-1: New Delhi Metallo-beta-lactamase
NDM-1 is a resistance gene that bacteria carry, not a specific bacteria species. This gene codes for an enzyme that destroys most beta-lactam antibiotics — the largest and most important antibiotic class.
First identified in India, NDM-1-carrying bacteria have now spread globally. They appear in urinary tract infections, bloodstream infections, and wound infections. Many patients acquire NDM-1 bacteria after medical procedures abroad, then carry them home.
What makes NDM-1 particularly dangerous is how easily bacteria share this resistance gene. Multiple different bacteria species can acquire NDM-1, and they can pass it to other bacteria rapidly.
Gonorrhea: Toward Untreatable STIs
Neisseria gonorrhoeae — the bacteria causing gonorrhea — has developed resistance to every antibiotic class used to treat it. Penicillin, tetracycline, fluoroquinolones — all have failed as gonorrhea developed resistance.
Currently, doctors treat gonorrhea with injectable ceftriaxone plus oral azithromycin, but resistance to these drugs is emerging. Cases of gonorrhea resistant to all known antibiotics have already appeared.
If gonorrhea becomes fully untreatable, the consequences extend beyond the infection itself — untreated gonorrhea causes infertility, chronic pain, and increases HIV transmission risk. The prospect of an untreatable sexually transmitted infection spreading widely represents a serious public health threat.
Global Impact: The Devastating Consequences of Antibiotic Resistance
Rising Death Tolls
Antibiotic resistance already kills hundreds of thousands of people annually worldwide. Conservative estimates suggest at least 700,000 deaths per year globally, but the true number is likely much higher.
Projections warn that if current trends continue, antibiotic-resistant infections could kill 10 million people per year by 2050 — more than cancer currently kills. In this scenario, resistant infections would become the leading cause of death globally.
These deaths occur not just in poor countries with limited healthcare — they happen in modern hospitals in wealthy nations. Patients undergoing routine surgery develop post-operative infections that no antibiotic can treat. Cancer patients receiving chemotherapy die from infections their weakened immune systems cannot fight because antibiotics no longer work.
Economic Costs
The economic burden of antibiotic resistance is staggering and growing. Resistant infections require longer hospitalizations, more expensive drugs, additional medical procedures, and extended recovery periods.
The World Bank estimates that antibiotic resistance could cause economic damage comparable to the 2008 financial crisis. Healthcare costs could increase by trillions of dollars globally. Lost productivity from illness and death could reduce GDP significantly in many countries.
Individual families face financial ruin when a family member develops a resistant infection requiring months of hospitalization and expensive treatments that insurance may not fully cover.
Threat to Modern Medicine
Perhaps the most profound impact of antibiotic resistance is how it threatens the foundation of modern medicine. Many medical advances depend entirely on effective antibiotics.
Procedures at risk without effective antibiotics:
- Cancer chemotherapy: Chemotherapy weakens immune systems, making patients vulnerable to infections. Without working antibiotics, chemotherapy becomes far more dangerous
- Organ transplantation: Transplant recipients take immunosuppressant drugs and face high infection risk. Resistance makes transplants significantly riskier
- Surgery: All major surgery carries infection risk. As resistance spreads, routine surgeries could become life-threatening
- Joint replacements: Hip and knee replacements can become infected. If infections become untreatable, these life-improving procedures may become too risky
- Premature infant care: Fragile premature babies frequently develop infections and need antibiotics to survive
- Dialysis and other chronic treatments: Many chronic therapies involve devices that can become infected
Medicine could regress decades if antibiotics lose effectiveness. Procedures considered routine today could return to being highly dangerous.
Food Security and Agriculture
Antibiotic resistance threatens global food security in multiple ways. Livestock producers depend heavily on antibiotics to maintain productivity. If regulations restrict agricultural antibiotic use — as they must to slow resistance — food prices could increase and meat production could decline.
Conversely, if agricultural antibiotic use continues unchecked, resistance will accelerate, affecting human health more severely. Either path creates problems.
Additionally, farmers and agricultural workers face higher exposure to resistant bacteria than the general population. These individuals can carry resistant bacteria into communities, spreading the problem beyond farms.
Solutions to Antibiotic Resistance: Fighting Back Against Drug-Resistant Bacteria
Antibiotic Stewardship Programs
Healthcare systems worldwide must implement rigorous antibiotic stewardship programs that ensure antibiotics are prescribed only when truly necessary and that patients receive the right antibiotic for the right duration.
Key stewardship measures:
- Diagnostic testing before prescribing: Doctors should confirm bacterial infections before prescribing antibiotics
- Prescribing guidelines: Healthcare systems need clear protocols for when to prescribe specific antibiotics
- Audit and feedback: Monitoring prescription patterns and providing feedback to doctors who overprescribe
- Patient education: Teaching patients when antibiotics work and when they do not
- De-escalation protocols: Starting with broad antibiotics when necessary but switching to narrow-spectrum drugs once testing identifies the specific bacteria
Countries that implement strong stewardship programs show measurable reductions in antibiotic use and slower resistance development.
Strict Regulation of Agricultural Antibiotic Use
Governments must ban or severely restrict the use of medically important antibiotics in food-producing animals. Antibiotics should be used only to treat sick animals, never for growth promotion or routine disease prevention.
The European Union banned antibiotic growth promoters in 2006, demonstrating this change is feasible. Other countries must follow. Farmers need support transitioning to animal husbandry practices that maintain productivity without routine antibiotic use.
Sustainable alternatives to agricultural antibiotics:
- Improved hygiene and biosecurity: Cleaner facilities reduce disease spread without antibiotics
- Better animal nutrition: Well-nourished animals resist infections better
- Vaccination programs: Vaccines prevent diseases, reducing antibiotic need
- Lower stocking densities: Less crowding reduces disease transmission
- Selective breeding: Breeding animals for disease resistance
These practices work but require investment and may increase production costs initially.
Infection Prevention and Control
Preventing infections in the first place reduces antibiotic need. Healthcare facilities, schools, and communities must prioritize infection control measures.
Effective infection prevention strategies:
- Hand hygiene: Simple handwashing prevents enormous numbers of infections
- Sanitation infrastructure: Clean water, proper sewage treatment, and waste management reduce environmental bacteria
- Vaccination programs: Vaccines prevent bacterial infections, eliminating antibiotic need
- Isolation protocols: Separating patients with resistant infections prevents spread
- Surveillance systems: Tracking resistance patterns helps contain outbreaks early
Investment in public health infrastructure pays enormous dividends by preventing the infections that drive antibiotic use and resistance.
Development of New Antibiotics and Alternatives
Humanity urgently needs new antibiotics, but the current market model fails to incentivize pharmaceutical companies to develop them. Governments and international organizations must create new economic models that make antibiotic development financially viable.
Potential solutions:
- Government funding: Public investment in antibiotic research and development
- Market entry rewards: Large payments to companies that successfully bring new antibiotics to market
- Extended patents: Longer patent protection specifically for antibiotics
- Global pooled funding: International cooperation to fund antibiotic development
- Nonprofit drug development: Public institutions developing antibiotics without profit motive
Beyond traditional antibiotics, scientists explore alternative treatments:
- Bacteriophages: Viruses that specifically infect and kill bacteria
- Antibodies: Engineered antibodies that target specific bacteria
- Antimicrobial peptides: Natural molecules that kill bacteria through different mechanisms
- Microbiome manipulation: Using beneficial bacteria to outcompete harmful ones
- CRISPR and genetic approaches: New technologies that target bacterial DNA
Global Coordination and Surveillance
Antibiotic resistance recognizes no borders. Bacteria developing resistance in one country rapidly spread globally through travel and trade. Effective response requires unprecedented international cooperation.
The World Health Organization coordinates global resistance surveillance, but this system needs expansion and stronger enforcement. Countries must share resistance data transparently, implement common standards, and coordinate response strategies.
Essential global actions:
- Universal resistance surveillance: All countries tracking and reporting resistance patterns
- International prescribing standards: Common guidelines for appropriate antibiotic use
- Travel screening: Monitoring for resistant bacteria in international travelers
- Research collaboration: Sharing scientific knowledge and research findings globally
- Technology transfer: Helping developing countries implement resistance control measures
Public Education and Awareness
Most people remain unaware of antibiotic resistance or misunderstand how antibiotics work. Comprehensive public education campaigns must teach people:
- Antibiotics kill bacteria, not viruses
- Colds and flu are viral — antibiotics will not help
- Taking antibiotics exactly as prescribed is essential
- Never sharing antibiotics or saving them for later use
- Good hygiene prevents infections, reducing antibiotic need
- Antibiotic resistance is a serious threat requiring everyone’s participation
When people understand resistance, they make better choices about antibiotic use and support necessary policy changes.
What Individuals Can Do: Your Role in Fighting Antibiotic Resistance
While solving antibiotic resistance requires large-scale systemic changes, individuals can take meaningful actions that collectively make a difference.
Use Antibiotics Responsibly
- Never demand antibiotics from your doctor for viral infections like colds or flu
- Complete the full course when your doctor prescribes antibiotics, even if you feel better
- Never share antibiotics with others or use leftover antibiotics from previous prescriptions
- Ask questions: When prescribed antibiotics, ask if they are truly necessary and why
- Follow dosing instructions precisely — never skip doses or take incorrect amounts
Practice Good Hygiene
- Wash hands frequently with soap and water, especially before eating and after bathroom use
- Handle and cook food safely to kill bacteria in meat and prevent contamination
- Keep wounds clean and covered to prevent bacterial infections
- Stay home when sick to avoid spreading infections to others
- Get vaccinated — vaccines prevent infections, eliminating antibiotic need
Choose Food Wisely
- Buy meat labeled antibiotic-free or “raised without antibiotics” when possible
- Support farmers using sustainable practices that minimize antibiotic use
- Reduce meat consumption — less demand for industrial meat production reduces agricultural antibiotic pressure
- Cook meat thoroughly to kill any resistant bacteria present
Advocate for Change
- Support policies regulating antibiotic use in agriculture and healthcare
- Vote for leaders who prioritize public health and antibiotic resistance
- Educate others about antibiotic resistance and appropriate antibiotic use
- Support funding for antibiotic research and public health infrastructure
The Future of Antibiotic Resistance: Can We Prevent the Post-Antibiotic Era?
The trajectory of antibiotic resistance is deeply concerning, but the future remains unwritten. Whether humanity faces a catastrophic post-antibiotic era or successfully manages resistance depends on choices made today.
Worst-Case Scenario
If current trends continue unchecked, the future is grim. Common infections become untreatable killers. Minor injuries risk becoming fatal. Surgery, chemotherapy, and organ transplantation become too dangerous to perform routinely. Childbirth mortality returns to pre-1940s levels. Life expectancy drops significantly. Healthcare costs soar while effectiveness plummets.
This scenario is not inevitable, but it approaches certainty if action is not taken urgently and comprehensively.
Optimistic Scenario
Alternatively, if humanity treats antibiotic resistance with the urgency it deserves, progress is possible. Strong international cooperation could slow resistance development significantly. New antibiotics and alternative therapies could provide options when current drugs fail. Improved infection prevention could reduce the infections requiring antibiotic treatment. Better stewardship could preserve existing antibiotics’ effectiveness longer.
This future requires political will, sustained investment, global cooperation, and public participation. It requires treating antibiotic resistance as the global health emergency it truly is.
The Window of Opportunity
The window for effective action is closing but not yet closed. Every year of delay makes the problem harder to solve and increases the eventual human cost. The decisions humanity makes in the next decade will largely determine whether future generations inherit a world where antibiotics work or one where simple infections kill millions.
The question is not whether antibiotic resistance can be slowed — it can. The question is whether humanity will choose to act decisively before it is too late.
Conclusion: The Urgent Fight Against the Silent Pandemic
Antibiotic resistance is perhaps the perfect modern health threat — a crisis largely caused by humanity’s own actions, accelerating silently until suddenly becoming catastrophic, solvable with coordinated global action yet challenged by economic incentives and political inertia.
The bacteria that antibiotics once easily defeated now threaten to reclaim their ancient dominance over human health. The medical advances of the past 80 years — the surgeries, the cancer treatments, the organ transplants, the premature infant care — all rest on a foundation of effective antibiotics. That foundation is cracking.
But unlike many global threats, antibiotic resistance is not inevitable. It stems from choices — how doctors prescribe, how patients use antibiotics, how farmers raise livestock, how pharmaceutical companies invest in research, how governments regulate and fund public health.
Different choices can produce different outcomes. Stricter antibiotic stewardship can work. Banning agricultural growth promotion antibiotics can work. Investing in new drug development can work. Better infection control can work. These solutions exist and have proven effective where implemented seriously.
The silent pandemic of antibiotic resistance threatens everyone, regardless of wealth, geography, or health status. Anyone can develop a resistant infection. Everyone depends on antibiotics working for surgery, childbirth, and routine medical care.
This is humanity’s fight to lose. The bacteria will do what evolution programs them to do — survive and adapt. Only humans can choose to act strategically, cooperate globally, and implement the changes necessary to preserve antibiotics for future generations.
The question is not whether antibiotic resistance is a serious threat — it unquestionably is. The question is whether humanity will treat it as such and act accordingly before the window for effective action closes permanently.
The silent pandemic is here. The time to respond with urgency is now.
